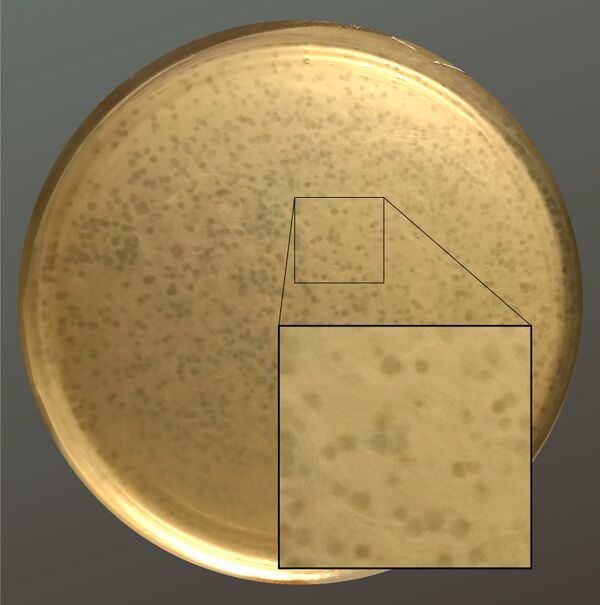

Бактериофаги
Бактериофа́ги, или фа́ги (от др.-греч. φᾰ́γω «пожираю») — это вирусы, заражающие бактериальные клетки. Ранее бактериофагами называли и вирусы архей, однако в настоящее время этот термин принято относить исключительно к бактериальным вирусам. Бактериофаги, как и любые иные вирусы, размножаются внутри клетки хозяина. Высвобождение потомства большинства бактериофагов происходит путём лизиса инфицированной бактериальной клетки, однако при размножении бактериофагов некоторых групп, например, нитчатых фагов, выход вирусных частиц происходит без разрушения клетки, которая сохраняет свою жизнеспособность. Вирусная частица или вирион бактериофага состоит из оболочки, как правило белковой, и генетического материала одноцепочечной или двуцепочечной нуклеиновой кислоты (ДНК или, реже, РНК). Общая численность бактериофагов в большинстве природных местообитаний примерно равна численности бактерий или превышает ее в 2—10 раз, при этом общее количество фаговых частиц в Биосфере Земли составляет 1030—1032 частиц[1]. Бактериофаги активно участвуют в круговороте химических веществ и энергии, оказывают заметное влияние на состав, динамику и активность микробных сообществ, влияют на эволюцию микробов, на их взаимодействия между собой и с многоклеточными организмами и даже участвуют в контроле экспрессии собственных генов микроорганизмов[1][2]. У бактерий существует также большое число генетических элементов и кодируемых ими молекулярных структур, имеющих общее происхождение с бактериофагами, "приспособленных" микробами для тех или иных собственных нужд: дефектные профаги, бактериоцины R и F типов, AFP профаги (от англ. antifeeding prophage - профаги, препятствующие питанию), системы секреции VI типа (T6SS), сократимые системы, ассоциированные с метаморфозом (MAC), агенты переноса генов (GTA - gene tranfer agents) и другие[2]. Бактериофаги, а также антивирусные (противофаговые) системы бактерий послужили источником большей части инструментария современной Генетической инженерии и ряда других технологий[2].
Общие сведения
История
К концу XIX столетия микробиология была достаточно развитой наукой, в которой активно работало значительное число исследователей, а также практических специалистов-бактериологов, занятых в клинике и на некоторых производствах. Более того, к началу XX века вирусы (по тогдашней терминологии фильтрующиеся вирусы) уже были известны: в 1892 году Дмитрием Ивановским был открыт вирус табачной мозаики, а в 1898 году Фридрихом Лёфлером и Паулем Фрошем был описан вирус ящура. С высокой долей вероятности многие исследователи встречались с явлением бактериофагии. Известно несколько десятков статей, вышедших до 1915 года, которые сообщают об эффектах, сходных с бактериофагией[3], среди которых наиболее известны работы Э. Ганкина (E. Hankin), в 1896 году описавшего литическое действие фильтрата воды реки Ганг на холерного вибриона[3], а также работа Н. Ф. Гамалеи, наблюдавшего в 1897 году явление лизиса бактерий (сибиреязвенной палочки) под влиянием перевиваемого агента[3][4]. В 1915 году английский микробиолог Фредерик Туорт описал так называемое стекловидное перерождение колоний стафилококков, возбудитель которого проходил через фарфоровые бактериальные фильтры, и его можно было переносить от одной колонии к другой. Туорт охарактеризовал этот агент как вирус, заражающий бактерии и даже выдвинул предположение о возможном эволюционном происхождении вирусов из доклеточных форм жизни[4][5].
Независимо от Фредерика Туорта франко-канадский микробиолог Феликс д’Эрелль сообщил в 1917 году об открытии вируса возбудителя дизентерии, который он назвал бактериофагом[4][6]. Важнейшим достижением д’Эрелля была верная интерпретация стерильных пятен (бляшек), образующихся в сплошном слое бактериального роста на плотной среде (так называемом газоне) под действием разбавленной суспензии фага как индивидуальных негативных колоний бактериофага. Д’Эрелль сделал верное заключение, что в большинстве случаев бляшка формируется из отдельной фаговой частицы, что приводило, во-первых, к заключению о корпускулярной природе фага (в противоположность гипотезе о растворимом токсине, имеющем минимальную действующую концентрацию), а во-вторых дало возможность практического измерения концентрации активных фаговых частиц (или, точнее, бляшкообразующих единиц) в суспензиях. Возможность простой визуализации фагов и определения их концентрации методом посева сыграла ключевую роль в дальнейших исследованиях природы бактериофагов.
После открытия явлений бактериофагии д’Эрелль развил учение о том, что бактериофаги, обитающие в кишечнике человека и животных, способны адаптироваться к размножению на патогенных бактериях, и играют ключевую роль в естественном иммунитете, обеспечивая выздоровление больного организма даже в большей степени, чем известные в то время клеточные и гуморальные факторы иммунитета[7][8][4]. Это положение привлекло к напряженному научному противостоянию д’Эрелля и его сторонников с Жюлем Борде и его школой, которые пытались доказать, что бактериофагия не является результатом действия специфического паразита, но возникает в результате внутреннего «физиологического дисбаланса» бактерий[4][8]. Это противостояние хотя и привлекло к проблеме бактериофагии внимание ряда ученых, несколько задержало широкое признание взглядов д’Эрелля на бактериофаг как на ультрамикроскопический организм. Окончательно эти споры были разрешены только благодаря применению электронного микроскопа, которое в начале 1940-х позволило напрямую наблюдать вирионы бактериофагов[4].
Тем не менее, уже в 1922 году немецкий генетик Герман Мёллер, опираясь на результаты д’Эрелля и сотрудника Ж. Борде Андре Грациа сделал предположение, что «тельца д’Эрелля» (бактериофаги) представляют собой гены, способные к передаче (выражаясь современным языком, предположил, что бактериофаги являются трансмиссивной генетической программой), что, по мнению Мёллера, позволяло «атаковать проблему гена под совершенно новым углом» и давало надежду, что генетики скоро смогут «растирать гены в ступке или запекать в печи»[9][4].
В 1940-х — в начале 1950-х годов, результате работ так называемой фаговой группы, неформальным лидером который был Макс Дельбрюк, а также группы Джошуа Ледерберга и ряда других исследовательских коллективов, данная гипотеза была полностью подтверждена. В 1930—1950-е годы многие исследователи работали также над раскрытием механизмов лизогении, которая была впервые описана д’Эреллем и Борде, которые, однако, не смогли верно интерпретировать свои наблюдения. Окончательно проблема была разрешена в результате работ групп Андре Львова во Франции и Д. Ледерберга. Ими было показано, что профаг — генетический материал умеренного бактериофага содержится в каждой лизогенной клетке, но проявляется лишь в некоторых в процессе так называемой индукции. Более того, удалось продемонстрировать, что профаги не просто присутствуют в клетке, но интегрируются в её собственный генетический аппарат — хромосому[10][4]. Эти работы (в сочетании с развивавшимися в то же время исследованиями по генетике бактерий) заложили основы молекулярной генетики и молекулярной биологии и привели к созданию современной концепции вируса как трансмиссивной генетической программы, а также концепции провируса — временно «спящей» формы некоторых вирусов, интегрированной в клеточный геном.
Помимо своих пионерских исследований, касающихся природы бактериофага, Ф. д’Эрелль также предложил вводить полученный in vitro бактериофаг в качестве средства лечения бактериальных инфекций[7][4]. Этот подход известен как фаговая терапия. По сообщениям самого д’Эрелля в его руках метод фаговой терапии характеризовался впечатляющей эффективностью[7], и в 1920—1930-е годы эта технология была крайне популярна на Западе, а также в СССР. Однако, нестабильные результаты лечения бактериофагами, а также появление сульфаниламидных препаратов и антибиотиков привели практически к исчезновению интереса к фаговой терапии в Западной медицине[11][4]. В СССР (а после распада страны — в России и Грузии) этот метод продолжал применяться. В 2010—2020-х годах фаговая терапия вновь рассматривается как перспективный метод борьбы с бактериальными инфекциями, потенциально способный сгладить последствия глобального кризиса, вызванного распространением устойчивости к антибиотикам[12][13].
Роль бактериофагов в биосфере
Бактериофаги представляют собой наиболее многочисленную, широко распространённую в биосфере и, предположительно, наиболее эволюционно древнюю группу вирусов[2][14][15]. Приблизительный размер глобальной популяции фагов составляет более 1030 фаговых частиц[16].
В природных условиях фаги встречаются в тех местах, где есть чувствительные к ним бактерии, причем в некоторых экосистемах, например в водоемах, численность фаговых частиц превышает численность бактерий в 2—10 раз. Как правило, чем богаче тот или иной субстрат (почва, выделения человека и животных, вода и т. д.) микроорганизмами, тем в большем количестве в нём встречаются соответствующие фаги, но имеются и исключения.
Косвенно измеряемый вклад фаговой инфекции в суточную смертность бактерий составляет 10—70 % в зависимости от конкретного местообитания.
Несмотря на большое количество фаговых частиц в природных средах, выделение в культуру бактериофагов к конкретным штаммам бактерий, присутствующих в этих средах, далеко не всегда просто. Причины этой аномалии, а также механизмы, стабилизирующие сосуществование фагов и чувствительных к ним бактерий, многообразны и не до конца понятны. Важную роль играет большое разнообразие штаммов бактерий и фагов в природных местообитаниях. Поскольку фаги, как правило, узкоспецифичны по отношению к хозяевам, абсолютная концентрация микробных клеток каждого штамма и активных против них бактериофагов может быть низкой (хотя общая концентрация всех бактерий и всех фагов может быть достаточно высока[2][17]. В результате, как минимум в перемешиваемых системах (например, в воде), действует механизм kill the winner (убить победителя). В соответствии с ним давление фаговой инфекции на конкретную бактериальную популяцию возрастает по мере роста ее плотности. То есть, фаги вносят больший вклад в смертность экологически более успешных видов и штаммов по сравнению с минорными популяциями[2][17]. Более того, при лизисе бактериальной клетки бактериофагом большая часть биомассы бактерии преобразуется в мелкодисперсное растворимое органическое вещество, служащее питанием для других гетеротрофных бактерий. В результате, фаговая инфекция не только ограничивает размножение наиболее приспособленных видов, но и перераспределяет органическое вещество. По существующим моделям до 26 % всего объема первичной продукции органического вещества в морских экосистемах поступает в пул растворенного органического вещества в результате вирусного (в основном фагового) лизиса клеток различных организмов. Таким образом, фаговая инфекция поддерживает разнообразие бактерий и стимулирует их метаболическую активность, по меньшей мере в некоторых экосистемах.
Бактериофаги присутствуют в значительных количествах и в наземных экосистемах. Так, фаги, лизирующие клетки различных видов почвенных микроорганизмов, находятся в почвах. Особенно богаты фагами чернозёмы и почвы, в которые вносились органические удобрения. Вирусные сообщества (виромы), состоящие почти целиком из бактериофагов, ассоциированны и с микробиомом тела человека и животных, особенно многочисленны и разнообразны виромы кишечника[18]. Бактериофаги выполняют важную роль в контроле численности микробных популяций, в автолизе стареющих клеток, в переносе бактериальных генов, выступая в качестве векторных «систем»[2][19].
Предполагают, что виромы кишечника играют существенную роль в гомеостазе макроорганизма и в патогенезе некоторых заболеваний.
Бактериофаги также играют большую роль в эволюции бактерий. Посредством трансдукции они привносят в бактериальный геном новые гены или новые варианты имеющихся генов. Было подсчитано, что за 1 секунду в биосфере происходит около 1024 актов фаговой трансдукции бактерий[20].
Высокий уровень специализации, долгосрочное существование, способность быстро репродуцироваться в соответствующем хозяине способствует их сохранению в динамичном балансе среди широкого разнообразия видов бактерий в любой природной экосистеме. Когда подходящий хозяин отсутствует, многие фаги могут сохранять способность к инфицированию на протяжении десятилетий[21], однако в реальных экосистемах срок полужизни вирусных частиц составляет от нескольких часов до нескольких суток. Фаговые частицы инактивируются ультрафиолетовым облучением, могут необратимо связываться с различными частицами, гибнут в результате непродуктивной инфекции физиологически неактивных или мертвых клеток бактерий, могут выедаться некоторыми видами простейших, разрушаются под действием многих иных факторов. В большинстве случаев суточная продукция фаговых частиц уравновешивается их разрушением.
Строение бактериофагов
Бактериофаги различаются по химической структуре, типу нуклеиновой кислоты, морфологии и характеру взаимодействия с бактериями. По размеру фаги в сотни и тысячи раз меньше микробных клеток.
Типичная фаговая частица (вирион) состоит из головки и хвоста. Длина хвоста обычно в 2—4 раза больше диаметра головки. В головке содержится генетический материал — одноцепочечная или двуцепочечная РНК или ДНК с ферментом транскриптазой в неактивном состоянии, окружённая белковой или липопротеиновой оболочкой — капсидом, сохраняющим геном вне клетки[22].
Нуклеиновая кислота и капсид вместе составляют нуклеокапсид. Бактериофаги могут иметь икосаэдральный капсид, собранный из множества копий одного или двух специфичных белков. Обычно углы состоят из пентамеров белка, а опора каждой стороны из гексамеров того же или сходного белка. Более того, фаги по форме могут быть сферические, лимоновидные или плеоморфные[14].
Хвост, или отросток, представляет собой белковую трубку — продолжение белковой оболочки головки, в основании хвоста имеется АТФаза, которая регенерирует энергию для инъекции генетического материала. Существуют также бактериофаги с коротким отростком, не имеющие отростка и нитевидные[23].
Головка округлой, гексагональной или палочковидной формы диаметром 45—140 нм. Отросток толщиной 10—40 и длиной 100—200 нм. Одни из бактериофагов округлы, другие нитевидны, размером 8×800 нм. Длина нити нуклеиновой кислоты во много раз превышает размер головки, в которой находится в скрученном состоянии, и достигает 60—70 мкм. Отросток имеет вид полой трубки, окружённой чехлом, содержащим сократительные белки, подобные мышечным. У ряда вирусов чехол способен сокращаться, обнажая часть стержня. На конце отростка у многих бактериофагов имеется базальная пластинка, от которой отходят тонкие длинные нити, способствующие прикреплению фага к бактерии. Общее количество белка в частице фага — 50—60 %, нуклеиновых кислот — 40—50 %[24].
Фаги, как и все вирусы, являются внутриклеточными паразитами, и не способны к самостоятельному размножению. Хотя они содержат всю информацию для запуска собственной репродукции в соответствующем хозяине, у них нет механизмов для выработки энергии и рибосом для синтеза белка. Размер известных фаговых геномов варьирует от нескольких тысяч до 498 тысяч пар оснований (геном фага G, поражающего бацилл)[25][26].
Классификация бактериофагов
Большое количество выделенных и изученных бактериофагов определяет необходимость их систематизации. Этим занимается Международный комитет по таксономии вирусов (ICTV). В настоящее время, согласно Международной классификации и номенклатуре вирусов, бактериофаги разделяют в зависимости от типа нуклеиновой кислоты и морфологии.
Бактериофаги объединены в класс Bacteriophagae. На данный момент выделяют девятнадцать семейств. Из них только два РНК-содержащих и только пять семейств имеют оболочку. Из семейств ДНК-содержащих вирусов только два семейства имеют одноцепочечные геномы. У девяти ДНК-содержащих семейств геном представлен кольцевой ДНК, а у других девяти — линейной. В 2000 году считалось, что девять семейств специфичны только для бактерий, остальные девять только для архей, а представители семейства Tectiviridae инфицируют как бактерий, так и архей[27][28].
| Порядок | Семейство | Морфология | Нуклеиновая кислота | Пример |
|---|---|---|---|---|
| Caudovirales | Myoviridae | Без оболочки, сократительный хвост | Линейная дцДНК | Фаг Т4, фаг μ, PBSX, P1Puna-like, P2, I3, Bcep 1, Bcep 43, Bcep 78 |
| Siphoviridae | Без оболочки, несократительный хвост (длинный) | Линейная дцДНК | Фаг λ, фаг T5, C2, L5, HK97, N15 | |
| Podoviridae | Без оболочки, несократительный хвост (короткий) | Линейная дцДНК | Фаг T7, фаг T3, P22, P37 | |
| Ligamenvirales | Lipothrixviridae | В оболочке, палочкообразные | Линейная дцДНК | Acidianus filamentous virus 1—3, 6—9 |
| Rudiviridae | Без оболочки, палочкообразные | Линейная дцДНК | Sulfolobus islandicus rod-shaped virus 1, 2 | |
| Неизвестен | Ampullaviridae | В оболочке, бутылкообразные | Линейная дцДНК | |
| Bicaudaviridae | Без оболочки, лемонообразные | Кольцевая дцДНК | ||
| Clavaviridae | Без оболочки, палочкообразные | Кольцевая дцДНК | ||
| Corticoviridae | Без оболочки, изометрические | Кольцевая дцДНК | ||
| Cystoviridae | В оболочке, сферические | Сегментированная дцРНК | ||
| Fuselloviridae | Без оболочки, лемонообразные | Кольцевая дцДНК | ||
| Globuloviridae | В оболочке, изометрические | Линейная дцДНК | ||
| Guttaviridae | Без оболочки, яйцевидные | Кольцевая дцДНК | ||
| Inoviridae | Без оболочки, нитевидные | Кольцевая оцДНК | M13 | |
| Leviviridae | Без оболочки, изометрические | Линейная оцРНК | MS2, Qβ | |
| Microviridae | Без оболочки, изометрические | Кольцевая оцДНК | ΦX174 | |
| Plasmaviridae | В оболочке, плеоморфные | Кольцевая дцДНК | ||
| Tectiviridae | Без оболочки, изометрические | Линейная дцДНК |
По форме бактериофаги подразделяются на следующие морфологические группы или типы:
- нитевидные фаги;
- мелкие фаги без отростка;
- кубические фаги с аналогом (рудиментом) отростка;
- фаги с коротким отростком (хвостом);
- фаги с длинным отростком и несокращающимся чехлом;
- фаги с длинным отростком и сокращающимся чехлом.
По спектру литического действия выделяют следующие группы бактериофагов:
- типовые (типоспецифические) бактериофаги (Т-фаги) взаимодействуют с отдельными типами (вариантами) бактерий внутри одного вида;
- моновалентные бактериофаги (монофаги) взаимодействуют с бактериями одного вида;
- поливалентные бактериофаги (полифаги) взаимодействуют с бактериями нескольких родственных видов.
По механизму взаимодействия с клетками бактериофаги подразделяются на вирулентные и умеренные. Вирулентные (литические) бактериофаги проникают в бактерии, размножаются в них и выходят из бактериальной клетки, вызывая ее лизис. Умеренные бактериофаги после проникновения в клетку встраивают свою нуклеиновую кислоту в геном бактерии и не вызывают её лизиса[28].
Жизненный цикл
По характеру взаимодействия бактериофага с бактериальной клеткой различают вирулентные и умеренные фаги[23]. Вирулентные фаги могут увеличиваться в количестве только посредством литического цикла[21]. Умеренные бактериофаги после деления клетки находятся в состоянии профага (лизогенный цикл).
Начальные этапы взаимодействия с бактериальной клеткой одинаковы для умеренных и вирулентных бактериофагов. Бактериофаги прикрепляются к фагоспецифическим рецепторам на поверхности бактериальной клетки. Хвост фага с помощью ферментов, находящихся на его конце (в основном лизоцима), локально растворяет оболочку клетки, сокращается и содержащаяся в головке ДНК инъецируется в клетку, при этом белковая оболочка бактериофага остаётся снаружи.
При инициации литического цикла, инъецированная ДНК вызывает полную перестройку метаболизма клетки: прекращается синтез бактериальной ДНК, РНК и белков. Нуклеиновая кислота фага реплицируется. Репликация ДНК бактериофага происходит по полуконсервативному механизму и осуществляется с участием собственных ДНК-полимераз. ДНК бактериофага начинает транскрибироваться с помощью собственного фермента транскриптазы, который после попадания в бактериальную клетку активируется. Синтезируются сначала ранние, а затем поздние мРНК, которые поступают на рибосомы клетки-хозяина, где синтезируются, соответственно, ранние (ДНК-полимеразы, нуклеазы) и поздние белки бактериофага (белки капсида и хвостового отростка, ферменты лизоцим, АТФаза и транскриптаза). После синтеза поздних белков и завершения репликации ДНК наступает заключительный процесс — созревание фаговых частиц или соединение фаговой ДНК с белком оболочки и образование зрелых инфекционных фаговых частиц[30]. Продолжительность этого процесса может составлять от нескольких минут до нескольких часов[21]. Затем происходит лизис клетки, и освобождаются новые зрелые бактериофаги[23].
При инициации лизогенного цикла, генетический материал фага обратимо взаимодействует с генетической системой клетки-хозяина, интегрируясь в хромосому или сохраняясь в виде плазмиды[21]. Таким образом, вирусный геном реплицируется синхронно с ДНК хозяина и делением клетки, а бактериофаг в подобном состоянии называется профагом. Бактерия, содержащая профаг, становится лизогенной до тех пор, пока при определённых условиях или спонтанно профаг не будет стимулирован на осуществление литического цикла. Переход от лизогении к лизису называется лизогенной индукцией, или индукцией профага[20][31]. На индукцию фага оказывает сильное воздействие состояние клетки хозяина, предшествующее индукции, также как наличие питательных веществ и другие условия, имеющие место в момент индукции. Скудные условия для роста способствуют лизогенному пути, тогда как хорошие условия способствуют лизирующей реакции[21][23][30]. Известны случаи спонтанной индукции. Умеренные фаги из семейства Inoviridae способны стабильно воспроизводиться, не вызывая гибели клеток хозяина[32].
Специфичность бактерофагов
Спектр активности отдельных бактериофагов (англ. host range) часто ограничен культурами определённого вида бактерий. Существуют так называемые типовые бактериофаги, лизирующие варианты внутри вида. Также встречаются поливалентные бактериофаги, паразитирующие в бактериях разных видов[33][34]. Различают следующие типы спектра активности бактериофагов: адсорбционный, трансдуктивный, бактерицидный, продуктивный, бляшкообразующий и лизогенный[35]. Бляшкообразующий спектр активности определяется способностью фага образовывать бляшки на газоне бактерий. В то же время, при малом урожае фаговых частиц, продуктивная инфекция возможна без образования бляшек на бактериальном газоне. Распространённый метод тестирования литической активности на бактериальном газоне может давать ложноположительные результаты из-за лизиса бактериальных клеток без размножения вируса. Такой лизис может происходить вследствие адсорбции на бактериальной клетке большого количества фаговых частиц или активности свободных эндолизинов и бактериоцинов фагового препарата. В результате, определяемый в лаборатории спектр активности зависит от применяемой методики[36]. В исследовании 2021 года пять бактериофагов семейства Herelleviridae образовывали бляшки на 51—60 % штаммов S. aureus. Однако при совместном культивировании с бактериями в жидкой среде в течение суток те же бактериофаги были способны подавить рост только 2—49 % штаммов из той же коллекции[37].
Методы выделения фагов
Фаг получают и изучают в фильтратах исследуемого материала. О наличии и активности фага узнают по лизису чувствительной к нему культуры[38].
Подготовительный фильтрат вносят в бульонную культуру соответствующих микроорганизмов. Посев инкубируют - фаг размножается в клетках культуры и, соответственно, число (титр) активных фаговых частиц увеличивается. После этого бульон фильтруют и определяют свойства и активность фага[38].
Применение
Бактериофаги применяются в генной инженерии в качестве векторов, переносящих участки ДНК, возможна также естественная передача генов между бактериями посредством некоторых фагов (трансдукция).
Фаговые векторы обычно создают на базе умеренного бактериофага λ, содержащего двухцепочечную линейную молекулу ДНК. Левое и правое плечи фага имеют все гены, необходимые для литического цикла (репликации, размножения). Средняя часть генома бактериофага λ (содержит гены, контролирующие лизогению, то есть его интеграцию в ДНК бактериальной клетки) не существенна для его размножения и составляет примерно 25 тысяч пар нуклеотидов. Данная часть может быть заменена на чужеродный фрагмент ДНК. Такие модифицированные фаги проходят литический цикл, но лизогения не происходит. Векторы на основе бактериофага λ используют для клонирования фрагментов ДНК эукариот (то есть более крупных генов) размером до 23 тысяч пар нуклеотидов (т. п. н.). Причём, фаги без вставок — менее 38 т. п. н. или, напротив, со слишком большими вставками — более 52 т. п. н. не развиваются и не поражают бактерии[39].
Бактериофаги M13, фаг Т4, T7 и фаг λ используют для изучения белок-белковых, белок-пептидных и ДНК-белковых взаимодействий методом фагового дисплея.
Поскольку размножение бактериофага возможно только в живых клетках, бактериофаги могут быть использованы для определения жизнеспособности бактерий, например, с помощью метода электрооптического анализа клеточных суспензий[40].
Одной из областей использования бактериофагов является антибактериальная терапия, альтернативная приёму антибиотиков. Например, применяются бактериофаги: стрептококковый, стафилококковый, клебсиеллёзный, дизентерийный поливалентный, пиобактериофаг, коли, протейный и колипротейный и другие. Обычно бактериофаги эффективнее антибиотиков там, где присутствуют биологические мембраны, покрытые полисахаридами, через которые антибиотики обычно не проникают[41]. Применение бактериофагов в медицинских целях распространено в Грузии[42][43]. В России зарегистрировано и применяется 13 медицинских препаратов на основе фагов[1]. Их широко использовали для предотвращения дизентерии после наводнения 2012 года в Крымске[44]. По состоянию на 2000 год, терапевтическое применение бактериофагов не имело одобрения на Западе, хотя и применялись фаги для уничтожения бактерий, вызывающих пищевые отравления, таких как листерии[45]. В ноябре 2020 года фирма Adaptive Phage Therapeutics, американский производитель фаговых препаратов, заявила об одобрении использования бактериофагов в медицинских целях, выпущенном Управлением по санитарному надзору за качеством пищевых продуктов и медикаментов (FDA). С этой даты для пациентов с COVID-19 в США разрешена терапия сострадания пневмонии и бактеремии, обусловленных антибиотикорезистентными штаммами Acinetobacter baumannii, Pseudomonas aeruginosa и Staphylococcus aureus[46]. В сентябре 2021 года было известно о 45 клинических испытаниях фаговых препаратов. Из них 19 относились к США и 10 — к странам Евросоюза. На Россию и Грузию приходилось по одному исследованию[47].
Бактериофаги могут быть использованы для борьбы с важными для сельского хозяйства патогенами растений. Показана их применимость для обработки растений до сбора урожая и в послеуборочной обработке продукции. Для повышения эффективности и предотвращения развития резистентности у бактериального хозяина используются высокие титры литических фагов. Препятствием применения фаговых препаратов для защиты растений является чувствительность фаговых частиц к ультрафиолету. Для увеличения продолжительности жизни фагов в филлосфере фаги могут быть нанесены вечером. Устойчивую популяцию фагов на поверхности листьев можно создать путём использования различных вспомогательных препаратов, таких как обезжиренное молоко, смешанных с растворами фагов. Также возможно использование непатогенных бактерий-носителей, обеспечивающих размножение и выживание фагов на поверхности растений[48]. В экспериментах по оценке эффективности бактериофагов для защиты картофеля был показан пятикратный прирост урожайности[49].
См. также
Примечания
Ссылки
- Бактериофаги // Лекция к.б.н. К. Мирошникова в проекте ПостНаука (18.02.2013)